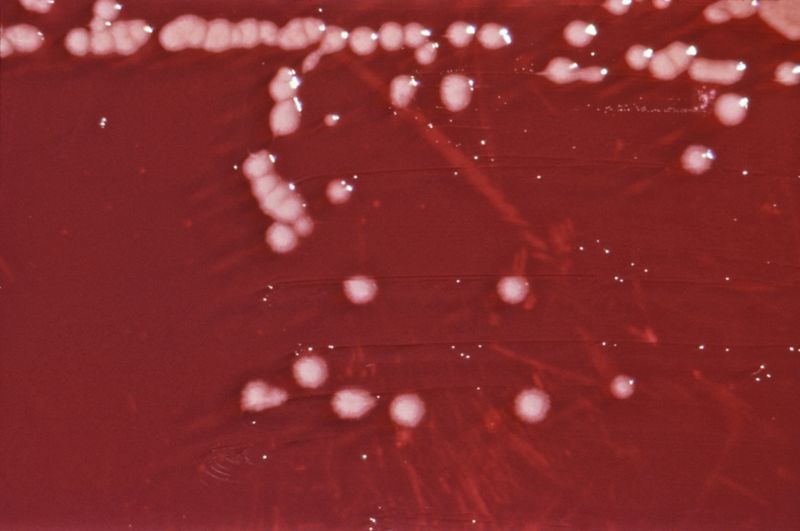
23-Pseudomonas-2

Questo batterio, come molti altri, attraverso le mutazioni sta trovando nuovi modi per evitare gli effetti degli antibiotici utilizzati cioè esistono dei ceppi che stanno sviluppando una resistenza ad alcuni antibiotici. Per cui occorre individuarlo attraverso indagini microbiologiche e gestire con attenzione la fase di sanificazione. Le Pseudomonas sono in grado di crescere a basse temperature e in condizioni ambientali non standard, quindi non sorprende che molte possano anche causare il deterioramento degli alimenti come ad esempio i latticini, le uova, la carne e il pesce.
Un numero relativamente elevato di Pseudomonas è in grado di formare biofilm. Cioè riescono nella secrezione di polisaccaridi appiccicosi nell'ambiente circostante le cellule. Grazie a ciò, i globuli bianchi hanno più difficoltà a liberarsi degli Pseudomonas nel corpo. Inoltre, questi batteri aderiscono meglio alla superficie ed è, ad esempio, molto più difficile rimuovere un simile biofilm dalla superficie degli utensili da cucina. Grazie alla formazione di biofilm, le Pseudomonas possono sopravvivere, ad esempio, anche nei contenitori in cui vengono prodotti i medicinali. Altri luoghi altrettanto degni di nota dove forse pochi si aspetterebbero la presenza di batteri sono i contenitori di composti antisettici di ammonio quaternario o anche nelle bottiglie di acqua minerale.
La più pericolosa Pseudomonas aeruginosa è presente nell'ambiente naturale e può essere rinvenuto anche nelle abitazioni, dove può diffondersi alle persone, specialmente in contesti sanitari, attraverso ceppi resistenti. È aerobico, ovvero richiede ossigeno per la crescita, e la sua forma è quella di bacilli Gram-negativi. Le colonie su terreni di coltura appaiono tipicamente pigmentate, con una tonalità verde-azzurra caratteristica. La produzione di pigmenti è dovuta a metaboliti specifici, che contribuiscono alla resistenza ambientale del batterio. I meccanismi di resistenza includono la produzione di enzimi che inattivano gli antibiotici. Questa resistenza può limitare le opzioni terapeutiche, rendendo essenziale lo sviluppo di nuove strategie di trattamento. In contesti sanitari, il batterio può diffondersi da una persona all'altra attraverso mani contaminate, attrezzature o superfici. Nel 2017, la Pseudomonas aeruginosa ha causato negli USA un numero stimato di 32.600 infezioni tra pazienti ricoverati e 2.700 decessi stimati. Nel corso degli anni, ci sono stati numerosi richiami di prodotti a causa della contaminazione da questo batterio. Le persone più a rischio di infezione sono i pazienti negli ospedali, specialmente quelli con macchine per la respirazione, dispositivi come cateteri o con ferite da interventi chirurgici o ustioni. La capacità del Pseudomonas aeruginosa di formare biofilm, comunità batteriche aderenti a superfici biologiche o artificiali, è una delle ragioni principali della sua persistenza negli ambienti sanitari. Gli infermieri e il personale di assistenza medica devono prestare particolare attenzione; ed in particolare oltre all'igiene delle mani, anche alla pulizia ambientale, in modo da ridurre il rischio di diffusione di questi germi ai pazienti.
Concludendo, la sua ubiquità nell'ambiente, la capacità di formare biofilm e la rapida evoluzione nella resistenza antibiotica richiedono una buobna capacità di eseguire indagini microbiologiche. La ricerca è essenziale per sviluppare strategie di trattamento efficaci e prevenire la diffusione di ceppi resistenti. Per affrontare questa minaccia microbiologica è comunque essenziale la sanificazione degli ambienti, sia essi in ambito ospedaliero, ma anche in abitazioni in cui ci sono persone allettate.
Se può interessare da oltre 10 anni i tecnici dell'A2C si occupano di minacce microbiologiche nelle abitazioni delle province di Salerno e Avellino; in particolare individuiamo e risolviamo le contaminazione attraverso una sanificazione personalizzata. Questo fa parte del più ampio servizio dell'A2C di difesa dalle minacce invisibile, tra cui ci sono anche le verifiche sul Radon, formaldeide e campi elettromagnetici.
#PseudomonasAeruginosa
#BatteriAmbientali
#ResistenzaAntibiotica
#SanificazioneAmbientale
#IndaginiMicrobiologiche
#Biofilm
#SalutePubblica
#IgieneOspedaliera
#MinacceMicrobiologiche
#AmbienteSano





